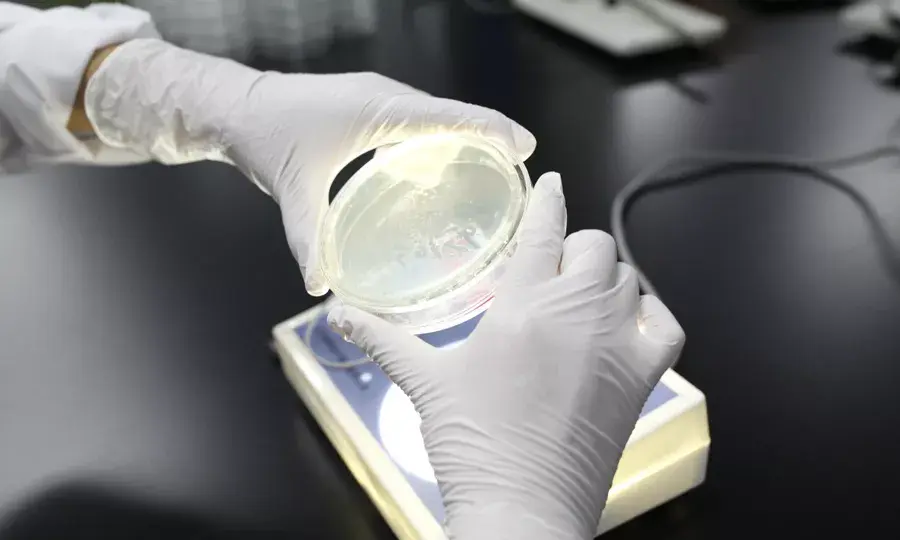

探秘名膜壹号“超级工厂”:一片无添加面膜的诞生
探秘名膜壹号“超级工厂”:一片无添加面膜的诞生
您是否好奇:日本人都跪服的名膜壹号纯粹无添加面膜,究竟是如何炼成?
今天小编就和4位膜粉一起,带你走进名膜壹号的“超级工厂”,揭秘一片无添加面膜的诞生之旅,满足你的好奇心!
无添加面膜的工厂到底有多“变态”?
这栋大楼,就是名膜壹号的“秘密基地”啦,它可是国内少有的国际一流科研中心!每片面膜都从这里“走”出!

进入厂区,整个作业间的空气都经过卫生空气处理机24h不断净化过滤,每小时换气≥500次,保证无尘无菌。

如果你想要进入生产间,那必须穿成这样

然后进行1分钟360°全身风淋的“变态”除菌消毒,如果是没有戴帽子的状态,估计瞬间会被吹成扫把头。

一进门,你就可以看到穿着无菌服的工作人员,有条不紊地进行称量、投料、发酵、灭菌、过滤、离心、提纯等操作!

工作人员告诉我们,市面上大多数面膜由于添加了防腐剂,原材料即使裸露在空气中也不会变质,通过简单的勾兑就能完成生产。
但名膜壹号的面膜液因为100%不添加防腐剂,因此它的每个生产环节容不得半点马虎!就这一个环节,名膜壹号的工艺时长就是普通面膜的近6倍。
无添加面膜的灌装是怎么保证无菌的?
面膜液生产完成后,为了保证面膜液不受污染,经由无菌管道,直接被输送至无菌灌装机进行灌装。而进入灌装间,必须进行二次更加严格的换装和消毒。

这就觉得麻烦了?告诉你,这里的工作人员,每隔2小时就需要重复1次完整的步骤,每15分钟就需要手部消毒一次!
咦,这台大机器是干什么用的?

你们敷在脸上的面膜,就是由这台“巨无霸”完成灌装的!仅灌装这一步,名膜壹号就投入了比别人更多的心血。斥巨资研发了全球独一无二的“无菌灌装”专利技术。有了它,100%无添加才能真正实现。

看到这里,很多人都感慨:哇!一片面膜生产出来真不容易啊,终于可以包装销售了!NO!还远着呢!
史上最严苛的面膜质检有哪些步骤?
为了保证产品安全,面膜灌装结束后,会由工作人员立即送到恒温36°的静置间恒温7天,再进行为期43天的静置。

这期间,工作人员会将每一片面膜放置在灯光下进行检查,看是否变色、是否有杂质、封口是否完好等。

一旦发现问题,该片面膜就会被当场销毁,该批次面膜也会被列入重点关注对象。全检后,每个批次的面膜会再一次被抽出一定数量,送去进行第4层质检——遵循欧盟CGMP生产标准的微生物检测。
面膜液经过质检员提取后,经过48小时培养,再用显微镜观察面膜的微生物情况。

质检员告诉我们,一旦发现菌落群,该批次的面膜将会被全部销毁!而如此严苛的微生物检测,贯穿发酵、灌装、恒温、静置等面膜生产的整个过程!
只有经历层层检测,精华依旧纯净、透明,无菌落、无任何杂质,这一批次的“无添加”面膜才算合格!一片“无添加”面膜才得以诞生!
膜粉参观心得
“整个工厂就是人民币的既视感!”




也许很多人会疑惑:生产一片面膜而已,需要这么麻烦吗?需要这么繁杂的生产工序吗?需要这么严苛的标准吗?需要那些动辄几百万、上千万的昂贵设备吗?
名膜壹号告诉你:绝对需要!
因为我们知道,金钱和利益并不是一个企业存在的全部!有些信念、尊严更值得去追求!我们必须做到,名膜壹号出厂的每一片面膜,都是安心的、高效的,带给每一位用户的体验都是美丽的、美好的,才能不辜负每一位用户的信任和支持,才能走得更远!
标签:
